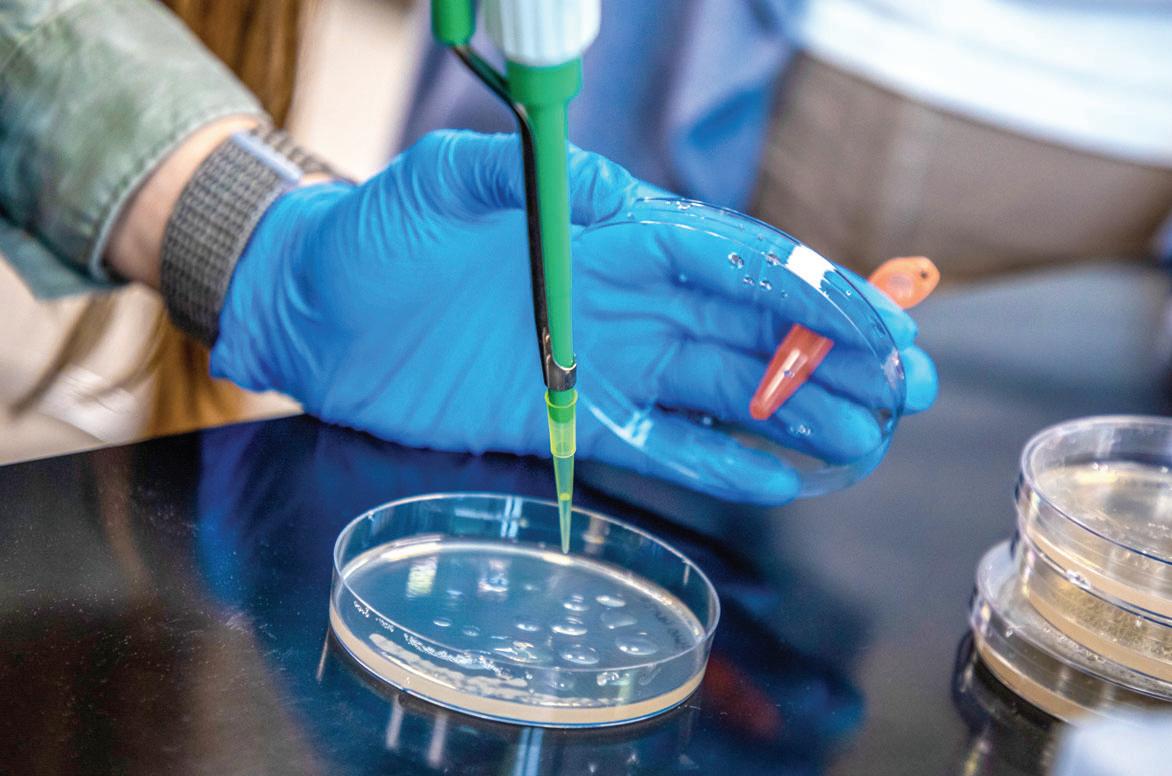

25 minute read
1,000 Words

Hired as Northwestern’s director of career and calling in 2019, Dr. Elizabeth Pitts is guiding Northwestern’s efforts to become the leading Christian college focused on student success and meaningful work.
Advertisement

Career &Calling
Northwestern makes preparing students for success and meaningful work central to its mission

BY ANITA CIRULIS
Major changes to Northwestern’s career services are having a signifi cant impact on students’ preparedness for life after college.
“Th e expectations of students and their parents are high for a fouryear degree,” says Julie Vermeer Elliott ’97, vice president for student life. “We really have to make it clear there’s a return on investment— that we can deliver on the outcomes we are promising.”
In response to that challenge, the Strategic Planning Committee adopted a new vision statement for Northwestern to be “the leading Christian college focused on student success and meaningful work for the common good.”
Guided by that vision, a committee of staff and faculty spent a year re-envisioning a new center focused on careers and calling. Th eir goals were to ground the center in a Christian understanding of the signifi cance of work in the life of faith, to better integrate the concept of vocation into academics and co-curricular programming, and to more eff ectively connect students with hands-on experiences that improve their work-readiness and leadership abilities.
Collaboration and networking with faculty, academic advisers, alumni, employers and student life staff were paramount, as was the development of student and faculty leaders trained to help students fi nd their calling from God.
Th e philosophical change also came with a physical change. Th e center’s offi ces were moved to the south side of the Ramaker Center, directly across from the campus ministry offi ces.
“I wanted higher visibility for the center itself,” Elliott says. “Th e location of career services next to campus ministry communicates that faith and work belong together. It says that helping students discern their calling is central to what we’re about in student development.”
Moving the center also allowed it to include an offi ce for the director of the Northwestern Network, who will increasingly focus on connecting students with alumni for internships, mentoring and job openings.
While the center was getting a new home, Dr. Elizabeth Pitts was hired as Northwestern’s director of career and calling in the fall of 2019.
“I could not have asked for a better leader,” Elliott says of Pitts. “She’s just outstanding in every way: her vision, her leadership, how good she is with students, the respect she commands from faculty. She has an ideal background.”
A Wheaton College graduate with a doctorate from George Mason University, Pitts has worked in Christian higher education for 20 years. Her fi rst job after graduating was in career services, and she spent 10 years with the Council for Christian Colleges & Universities—fi rst promoting CCCU off -campus study programs and then serving as a faculty member and internship director for the council’s American Studies Program.
“When I started interviewing for the role and realized what a huge vision they had—how integral they wanted to make it, the support they were willing to off er, and the resources to make this a really standout program—that’s when I became even more excited about the possibilities of this job,” she says.
Pitts and Elliott settled on Compass Center for Career & Calling as the new name for the center—a moniker that ties in with the directional nature of Northwestern’s name. Pitts quickly got to work on a framework that guides the center’s eff orts and makes sense to students, faculty, staff and parents. Th e Compass Center’s “navigation plan”—with its four components of explore, experience, equip and embark—was the result.
Pitts and her staff created 12 how-to guides for everything from creating a LinkedIn profi le to conducting a job search. Th ey launched a new

Micah Rens (right) was one of six students hired as Franken Fellows and trained to help other students prepare their professional portfolios.
Adulting 101
Preparation for life after college involves more than just choosing a career and fi nding a job.
During the 2020–21 school year, the Compass Center’s six peer career mentors, known as Franken Fellows, were charged with planning and presenting personal development events for their fellow students.
“Adulting 101” grew out of conversations that Dr. Elizabeth Pitts, director of career and calling, had with several Northwestern faculty members who recognized the need to teach students life basics not covered in the classroom.
Pitts made meeting that need an assignment for the Franken Fellows. “We had a brainstorming session about what they thought their peers wanted to know and what these faculty members were saying about those topics,” she says.
Each Franken Fellow student was assigned one session of the series, depending on his or her interests and abilities, and then paired with a content expert—for example, an accounting professor for the budgeting session.
The fi rst Adulting 101 class, “Meal Planning on a Dime,” taught students how to prepare three budget-conscious meals from one rotisserie chicken. Participants left with one prepped meal for the weekend, recipe cards and some handy meal-prep containers.
The session on fi nances covered budgeting essentials, tithing and paying off student loans, while an interactive session on health and fi tness explored the importance of maintaining a healthy lifestyle and a daily exercise routine.
Franken Fellow Emily Bosch, an accounting major, partnered with accounting professor Ray Gibler on the budgeting session.
“I actually spoke for part of my event, which was defi nitely a growing experience,” Bosch says. “We tried to create a cool incentive for students to come. We gave out cash to students, and Professor Gibler and I encouraged them to go out and be stewards of that money.”
The “Home Sweet Home” session provided an alumni panel discussing whether to rent or buy and how to fi nd a church, make new friends and build community. The fi fth Adulting 101 session focused on job benefi ts, covering things like co-pays, deductibles and premiums, and deciphering the meanings of HMO, PPO, FSA, HSA and 401(k).
Adulting 101 ended with “Dining Etiquette,” during which students enjoyed a catered, three-course meal while learning proper manners in a formal dining setting.
website (nwciowa.edu/compass-center), created in collaboration with Northwestern’s marketing and communications offi ce. And they’re building partnerships with faculty to get career preparation embedded into the curriculum from students’ initial First-Year Seminar course to their capstone Senior Seminar.
As of last fall, Northwestern students can also connect with one of six Franken Fellows—students hired by the Compass Center to serve as career mentors for their peers. Pitts and her staff , she says, “hired for heart and trained for technique.” Th e Franken Fellows participated in a three-day orientation in August that included hands-on learning and observation of Compass Center staff doing career counseling. Th ey prepared their own resumes, cover letters and online profi les and learned how to help others do the same.
“I love getting to know other students better and learning about them,” says Franken Fellow Emily Bosch. “Dr. Pitts talked about how we should be gold diggers for the students here at Northwestern. We should be able to draw out the gold inside of them for a resume or job interview—to help them see the good in themselves so they can serve God’s kingdom.”
Th e Franken Fellows are the Compass Center’s ambassadors, giving the center more visibility through events, programming and their presence at a “drop-in center.”
“Th ere’s a lot of talk about it on campus,” Bosch says of the Compass Center. “Our services are becoming more known thanks to our marketing eff orts and word of mouth.”
Chris Jelken, who graduated in May with a major in business administration–international business, was among the students who have taken advantage of the Compass Center’s services. Following weekly meetings with Pitts, he connected with a Franken Fellow to get help with his professional documents. He also worked with Compass Center staff and the director of the Northwestern Network to line up informational interviews with alumni.
“A lot of the people I interviewed just blew me out of the water with what their jobs meant to them, how God called them to where they are, and the path they followed to get there,” he says.
Now in the middle of a job search for which he feels well prepared, Jelken appreciates the support he gets from the Compass Center.
“It’s like I’m stepping into the boxing ring, and I have a team in my corner that is looking for opportunities and helping me win the fi ght and come out on top,” he says. “Th ey’re just great encouragers.” mselves so they can serve Gods ss Center’s ambassadors, giving ts, programming and their prespus,” Bosch says of the Compass re known thanks to our marketing with a major in business adminmong the students who have taken vices. Following weekly meetings n Fellow to get He also worked ector of the Northnal interviews with st blew me out of o them, how God path they followed r which he feels pport he gets from g ring, and I have opportunities and on top,”he says.



Karl Ford earned his Compass Center padfolio by taking the CareerExplorer aking the CareerExplorer inventory, lining up references, and preparing his resume, cover letter, and resume, cover letter, and LinkedIn and Handshake profi les. This fall he’ll help other students do the p other students do the same as one of the center’s Franken Fellows peer career mentors. career mentors.
LEM MAURER

Job Search Incentive
A resume, cover letter and references are essential for any job search. And in today’s digital world, profi les on LinkedIn and Handshake are increasingly as important.
Northwestern’s Compass Center staff want every student to graduate prepared for his or her job search, so they’re offering an incentive: Everyone who prepares those fi ve items and takes the CareerExplorer inventory is presented with a padfolio bearing the Compass Center logo.
In a fi nal end-of-semester push, Compass Center staff and the Franken Fellow peer career mentors hosted two evening help sessions featuring free pizza. “They brought in students I’ve never laid eyes on. They have access,” says Dr. Elizabeth Pitts, director of career and calling, of her student assistants.
By graduation, 75 students earned their padfolio and had what they needed to connect with potential employers.
says Dr. Elizabeth Pitts, director o and calling, of her student assista By graduation, 75 students ea their padfolio and had what they to connect with potential employ


LAB WORK
Only a select few colleges and universities have been accepted into the Howard Hughes Medical Institute’s SEA-GENES research program. Northwestern is one of them.
BY ANITA CIRULIS

Earn a biology degree from Northwestern, and you’re virtually guaranteed to graduate with research experience.
Five years ago, Northwestern was one of 20 colleges and universities accepted into the 2016–17 cohort of SEA-PHAGES, a national program designed to interest undergraduates in scientifi c research. Now nearly 150 institutions are part of a global eff ort to discover phages, or viruses that infect bacteria.
SEA-GENES is the next step in that research. Five colleges and universities in the U.S. were part of the fi rst cohort selected for SEAGENES. Eight—including Northwestern—were selected for the second cohort in 2020.
“Th ere are so many more opportunities for research,” says Dr. Sara Sybesma Tolsma ’84, professor of biology, of the impact of the program. “You don’t have to be the top of the class with all this extra time. You just take a couple of courses, and you’re doing it.”
Th ose courses are SEA-PHAGES: Discovery, a two-credit lab in which students discover and isolate phages; Genetics and Genomics, a four-credit course in which they annotate phage genomes; and SEAGENES, a two-credit lab in which they identify the functions of phage genes.
SEA-PHAGES comes with fi nancial support from the Howard Hughes Medical Institute’s Science Education Alliance. “It’s not a grant, but we get thousands of dollars’ worth of supplies—such as enzymes and primers—from them,” Tolsma says.
Each school in the SEA-GENES program is assigned a phage to research. Northwestern’s is named Island3.
“We’re cloning all 76 genes and then asking if any of those genes cause the host bacterial cell to die or grow more slowly—and if any prevent another virus from infecting the host cell,” Tolsma says.
Th ree students were enrolled in the inaugural SEA-GENES lab last fall: seniors Ali Almail and Sammy Blum and junior Lauren Pavich.
Blum, who graduated in May and is now enrolled in Northwestern’s physician assistant graduate program, gained an appreciation for what research involves. “I didn’t realize how much critical thinking and team collaboration goes into research,” she says.
Pavich—who will serve as Tolsma’s teaching assistant this fall—also enjoyed the collaborative nature of the class, citing times she, her classmates and Dr. Tolsma would have discussions about how to move forward when something wasn’t working.
“I enjoy research a lot,” she says. “I wasn’t very good at critical thinking before coming to Northwestern, but these programs have defi nitely made it easier to learn how to work through problems.”
Almail was grateful for the opportunity to search for answers to questions raised when he took Genetics and Genomics. He applied and was accepted into Northwestern’s Junior Scholars program, which allowed him to continue his search for a sequence of DNA, referred to as a “promoter,” that turns a gene on or off .
“He’s gotten some amazing data,” Tolsma says of Almail. “We think
Sammy Blum (left) and Ali Almail were two of the fi rst students to take the research-focused SEA-GENES lab from Dr. Sara Tolsma, professor of biology.

In SEA-GENES, students clone the genes of a bacteriophage as a step to determining their function.
we’ve characterized a promoter that’s never been characterized before.”
For this year’s national SEA Symposium, the conveners considered more than 80 abstracts for talks. Almail was one of fi ve students chosen to discuss their research results. He isn’t, however, the only Northwestern student with results to share from their research. Since Northwestern was accepted into the SEA-PHAGES program, more than 50 of the college’s students have produced peer-reviewed publications to add to their resumes.
Almail will begin studying at the University of Toronto’s medical school this fall and someday hopes to be a pediatric doctor and researcher. Th e majority of Northwestern’s biology department majors are interested in just practicing medicine, but Tolsma says research experience is invaluable for them as well.
“Th is helps them in their role as clinicians,” she says. “Th ey’ll be better able to interpret scientifi c evidence and to more critically evaluate research that might impact their patients.”
Ultimately, the research conducted through the SEA-PHAGES and SEA-GENES programs aligns with Northwestern’s goals to be a place where people use their minds to better understand, serve and love God’s world.
Th at’s what faculty and students do in the SEA-PHAGES and SEAGENES courses. Instead of canned labs and an emphasis on memorization, students experience real science that involves solving problems, interpreting data and thinking critically.
“I’m excited. I’m interested. I’m curious,” says Tolsma of the phage research taking place at Northwestern. “And when I look at the students, they’re excited, they’re interested and they’re curious. Both of those things give me life.”








A REEL EPIC
National runner-up season seems taken from the big screen
BY DUANE BEESON
Amovie scriptwriter couldn’t come up with a better plot line than the Northwestern football team’s 2020–21 season.
Start with a group of seniors who were recruited when the Raiders were 3-7 under their fi rst-year head coach. Over four years, their teams qualify for the national playoff s each season and lose only eight games.
Th row in a global pandemic that alters protocols for games and practices and upends the schedule. For the fi rst time ever, the season is extended into the spring semester after the Raiders fi nish 8-1 in the fall.
Focus on head coach Matt McCarty ’03, who emphasizes building a culture of pursuing excellence every day and overcoming adversity.
Show amazing footage of the NAIA’s national-player-of-theyear quarterback Tyson Kooima and his receiving corps, including three-time All-American Shane Solberg.
Use music to create tension as the Raiders travel to Des Moines to play second-ranked Grand View in a quarterfi nal-round playoff game April 24. Northwestern is down 14-0 early in the second quarter. A quarterback sack for a safety by Trevor Rozeboom at the start of the third period makes the score 14-9 and provides NWC momentum. With 1:03 left in the game, Eli Stader converts on a 21yard fi eld goal to give the Raiders a 27-24 victory.
Coach McCarty talks at practice the following week about the opportunity to face perennial nemesis Morningside in the semifi nalround game in Sioux City. News stories highlight the top-ranked Mustangs’ dominance. Th ey are the two-time defending national champions, boasting a 39-game winning streak, 10 straight GPAC titles, and seven consecutive wins over the Raiders.



Drone footage shows a crowded Olsen Stadium on May 1 as closeups of sweat-drenched players reveal the 90-degree temperatures. Potent off enses trade blows as the scoreboard advances. Visitors 9, Home 14 … 16-27 … 29-34 … 36-41.
With 1:49 remaining, the Raiders get the ball on their own 9-yard line. Kooima leads the team to the Morningside 23. Th e scoreboard shows 16 seconds left and third down as Kooima takes the snap, scrambles and heaves the ball into the end zone. A receiver, well defended, snags it for the go-ahead touchdown. Th e Raider receiver is Michael Storey, and it doesn’t take long for people to post on social media about Northwestern’s “Storey-book ending.”
But wait. As Raider fans go crazy, Kooima is in pain on the fi eld for several minutes. He has suff ered a debilitating Achilles heel injury and needs help getting to the sideline after setting a singlegame school record of 490 yards passing. Th e backup quarterback, who has attempted only 14 passes this season, comes in. Blake Fryar keeps the ball and runs for the two-point conversion, giving the Raiders a 44-41 lead.
Morningside moves into Northwestern territory, but Solberg— who hasn’t made a reception all game and is playing with a torn ACL and two broken ribs—breaks up the Mustangs’ Hail Mary pass with 2 seconds left. Northwestern is going to the national championship game for the sixth time in school history and the fi rst time since 1984.
In a press conference preceding the title contest versus Lindsey Wilson, reporters hurl question after question about how the Raiders can fare with Kooima on the sidelines.
“Tyson really transformed our program,“ McCarty responds. “He is such a playmaker. [But] when we were recruiting Blake, we felt he could help us win a championship. We have a ton of confi dence in him.
“Th is is the perfect group for such a unique year,” he continues. “Th ey really embraced all the adversity that came their way.”
Hundreds of cheering NWC fans line the road to the locker room as the Northwestern buses arrive at Grambling State University’s Eddie G. Robinson Stadium for the title game on May 10. “I got chills,” Coach McCarty later says. “Th at was pretty awesome.”
Early in the Red Raiders’ fi rst defensive stand, All-American safety Noah Van’t Hof suff ers a high-ankle sprain that renders him unable to compete. Quarterback Fryar throws for 157 yards and two touchdowns. But two Lindsey Wilson TDs in the third quarter give the Blue Raiders a 31-7 lead, and Northwestern falls, 45-13.
Th e next day, parents and fans greet the team in the Rowenhorst Student Center. “Red Raider fans are awesome,” McCarty tells the crowd. “It felt like home games in Des Moines, Sioux City and Louisiana. It’s a great feeling to be welcomed back.”
Th e team’s 10 graduating seniors—who were in Louisiana on the day of commencement—wear fl ip-fl ops or gym shoes and short pants under their gowns as they receive their diploma covers from President Greg Christy.
Later that week, Kooima undergoes surgery. Coach McCarty tells a reporter the quarterback is considering coming back next season since eligibility has been extended due to the pandemic. Th e doctor says an early fall return to action could be possible.
Fade to black.
Perhaps there will be a sequel?
ABOVE: Leading the Raiders to a national runner-up fi nish, Tyson Kooima was named the NAIA player of the year. He led the nation in passing, completing 65% of his attempts for 3,882 yards and 31 TDs, breaking numerous school records in the process.
RIGHT: More than 500 Red Raider fans cheered on the team at the national championship game in Grambling, Louisiana.
On the Web exclusive
Visit nwcraiders.com/football for more on the Raiders’ amazing run.


Michael Shields uses everyday household items and simple sporting equipment in his trickshot videos.
VIRAL
Trick-shot artist garners millions of followers on TikTok
BY JULIANA (PENNINGS ’12) BLOEMENDAAL
Michael Shields ’11 is hesitant to answer when asked to choose his favorite trick shot. “Th at’s like asking me to pick a favorite kid,” the father of four says with a laugh.
A fi nancial adviser with Edward Jones by day and a trick-shot artist by night, Shields has a niche on social media, garnering more than two million followers in the last 15 months.
His tricks range from tossing a marker into a glass bottle to throwing discs into a Wii console to chipping a table tennis ball into a water canister.
“Trick shots were always something I loved, but I never had time to create a presence online with them,” says Shields. Extra time at home during the COVID-19 pandemic, however, gave Shields the opportunity he’d been looking for.
Seeking a way to share his hobby, Shields turned to TikTok. “It was the easiest place to grow a following,” he says, noting that the social media platform was seeing an increase in popularity at the time.
He chose the name “Th at’ll Work” for his new brand. “I wanted the name to be fun and memorable, and also an antithesis to the idea that trick shots have to be perfect. Hence, ‘Th at’ll Work.’”
Shields posted his fi rst trickshot video in April 2020, featuring him chipping a roll of toilet paper—which was sparse at the time—onto a paper tower holder. “Th at trick should have been impossible,” he says. “But completing it inspired me to keep going.”
Th e satisfaction of routinely mastering next-to-impossible trick shots keeps Shields motivated, as does the feedback he receives. “Th e TikTok community is overwhelmingly positive,” says Shields, who receives thousands of comments per video, often such as “Th at was insane!” and “You just made my kid’s day!”
Shields recalls one follower’s heartwarming comment: Th e individual noted an ongoing illness, saying, “You motivate me to keep going because you never give up in your videos.”
As for the tricks themselves, Shields fi nds inspiration from various sources. “Half the inspiration is from other trick shots I see, but I add my own twist,” he says. “Th e others are random thoughts that pop in my head at 2 a.m.”
Th e majority of Shields’ videos are fi lmed at his Urbandale, Iowa, home—some in the living room, several in the backyard, and many in the basement. His wife, Brittany (Corlew ’12), occasionally assists. He records all of the videos on his cellphone, and he averages three new videos each week.
While some tricks only take a few hours to complete, Shields has spent days recording his most challenging shots. His longest to date—both in distance and time— was the feat of hitting a kickball off a baseball tee and into a basketball hoop that was 150 feet away. After nearly 12 hours at a local park, Shields made the shot.
What started as a hobby quickly developed into something much more than that, as Shields’ videos continually go viral. He’s been featured on ESPN’s SportsCenter seven times. “My initial goal was to build a new trick-shot brand and potentially do this as a career,” says Shields, adding that a career in trick-shot artistry is still his dream.
Shields doesn’t have any full sponsorships, but he does have occasional endorsements through which he will include a company’s product or apparel in his videos. (A former fi rst baseman and golfer for the Raiders, he has also worn his Northwestern gear while conquering a number of tricks.) Shields is selective when choosing his sponsorships, noting that they have to fi t his brand, the sports arena and his values.
With millions of social media followers, Shields doesn’t take his new and thriving following lightly. “Th ere are a lot of young kids who follow me on social media. I don’t want to present something to them that I wouldn’t want my kids seeing,” he says. “Th e music and words I choose leave an impact.”
Shields’ TikTok profi le also draws attention, as it includes the text “Jesus saves.”
“I’ve had a number of kids reach out asking about that, and I get to share the gospel with them,” says Shields. “I’m trying to fi gure out how to do that more.”
LON MONAHAN
For Michael Shields’ latest trick shots, follow @thatll.work on TikTok and Instagram.

Like Daughters, Like Mother Like Mother Like Mother
Family celebrates two graduates during Northwestern commencement
BY D UANE B EESON
Kelli Bosch remembers the feeling she had while sitting in Christ Chapel during her oldest daughter Katie’s RED101 visit.
“It just felt like home—a place where she would grow so much in her walk with the Lord, study in a great nursing program, and have the opportunity to run cross country and track,” she says. “And Katie did have a wonderful experience at Northwestern.”
Little did Kelli know the impact Katie’s decision to attend NWC would make on their family.
Two years later, younger daughter Emily chose to follow in Katie’s footsteps. “I got to visit her a lot, and I fell in love with Northwestern,” Emily says, echoing her mother’s sentiment. “I really felt like this was where I was meant to be.”
When Emily was a sophomore, Kelli decided to go back to school to earn a master’s degree. A fourth grade teacher in Des Moines, she wanted to prepare herself to move into an administrative position.
Because of her daughters’ experiences, she says, “Th ere was no other place I wanted to go.”
Th is May, the Bosches’ Northwestern experiences came full circle. Emily walked across the commencement stage having earned a bachelor’s degree in accounting, business education and secondary education. Several moments later, Kelli received the hood recognizing her completion of an online master’s degree in educational administration.
Emily says she is proud of her mother. “Not many people can stay home for 15 years, have fi ve kids, then do schoolwork while doing a full-time job,” she told the Des Moines Register.
Th e two found ways to assist each other on their college journeys. Emily helped her mother with the technological challenges of putting together an education portfolio, and Kelli provided advice as Emily worked on lesson plans and reviewed her experiences in the classroom.
“Th e graduate program energized me,” says Kelli. “I was reminded of the reason I’m here. And the professors are wonderful—very accommodating and encouraging. At just the right time, I’d get an email from a professor saying, ‘You can do this.’”
Emily was an all-conference and NAIA Scholar-Athlete softball player who served as a peer mentor in the Compass Center for Career & Calling, an admissions student ambassador, and a member of the Campus Ministry Team. She is already thinking about earning an MBA and possibly becoming a professor.
Her mom’s advice? “Don’t wait as long as I did to go back to school!”
May 8 didn’t mark the end of the Bosch family’s experience at Northwestern. Youngest daughter Megan will enroll in the fall.
DOUG BURG
